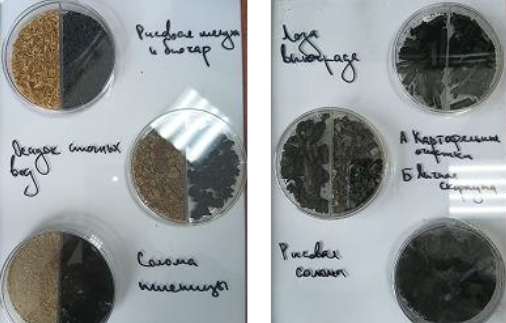

Углеродистые сорбенты, нанокомпозиты и биоудобрения
Область применения:
Биосорбенты, добавки для повышения плодородия почв, материалы для очистки сточных вод.
Восстановление почвы после техногенных и боевых воздействий, снижение рисков вторичного загрязнения и повышение устойчивости экосистем.
Основные технические характеристики:
- Удельная поверхность – не менее 100 м²/г;
- Суммарный объем пор – не менее 0,3 см3/г;
- Содержание углерода – не менее 90%;
- Распределение пор по размерам:
- Микропоры (< 2нм) – 15-30%
- Мезопоры (2-50 нм) – 60-70%
- Макропоры ( > 50 нм) – 15-20%
- Средний диаметр пор – 2,5-4 нм
- Зольность < 10%;
- Высокая химическая стабильность ( > 1000 лет);
- Высокая сорбционная емкость по отношению к различным поллютантам (до 95% удаления).
Краткое описание проекта:
Проект направлен на создание устойчивых технологий переработки органических отходов с получением био- и гидроуглей путем пиролиза и гидротермальной карбонизации. Полученные продукты обладают развитой пористой структурой, высокой удельной поверхностью и способностью к адсорбции различных токсинов, тяжелых металлов и органических загрязнителей. Преимущества проекта заключаются в использовании возобновляемого сырья (биомассы), отсутствии прямых аналогов по совмещению экологической и восстановительной функций, а также в универсальности применения.